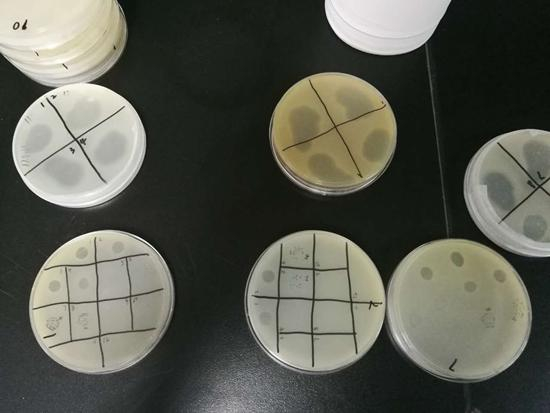
中科院武汉病毒研究所实验室中的噬菌体培养皿

中科院武汉病毒研究所实验室中的噬菌体培养皿
中科院武汉病毒研究所实验室中的噬菌体培养皿
静脉注射噬菌体后的 48 个小时之内,加州大学圣地亚哥医学院教授托马斯·帕特森缓缓睁开了眼睛。由于细菌感染,他已经昏迷了两个月。他从枕头上抬起头来,认出了自己的女儿并吻了吻她的手。很快,帕特森的血压开始稳定,白血球计数也开始下降。
噬菌体正通过他的血管,抵达他被感染的脏器,然后,干掉那些差点杀死了他的细菌。 “噬菌体是我们最后能用的一招了。”帕特森的妻子、加州大学圣地亚哥全球健康研究所所长斯蒂芬妮·斯特拉斯迪告诉中国青年报·中青在线记者,“这是我做过的最可怕的事,我知道我基本上把他的身体献给科学了,但它 (噬菌体) 起作用了!”
“起作用”的噬菌体,是一种专门“捕食”细菌的病毒。它们可以附着在细菌的细胞上,入侵并杀死细菌,是细菌在自然界中的天敌。据推测,噬菌体是地球上数量最庞大的生物体,约有 1031 种,比细菌的总数多了超过 10 倍。每一种噬菌体,都只能感染一种或几种特定的细菌菌株。
托马斯·帕特森不是第一个接受噬菌体治疗的人,但他是北美第一个用静脉注射噬菌体的方式,完全治疗全身性感染的人。当中国科学院武汉病毒研究所诊断微生物学学科组组长危宏平在朋友圈里刷到这条新闻时,他觉得这将是一个契机,“可以让噬菌体的研究得到社会更多的重视”。
在危宏平的实验室里,不同种类的噬菌体,正躺在培养皿里“捕食”着各个种类的细菌,等待被进一步地研究。
这些吃细菌的小病毒,现在或许是这个星球上最古老也最受欢迎的生物之一了。
“你觉得噬菌体疗法怎么样?”“这是个有趣且引人入胜的想法。”“我们没有这样做过,但我们认为是时候了。”
托马斯·帕特森是在埃及的金字塔里,遭受细菌感染的。
2015 年年底,他和妻子斯蒂芬妮·斯特拉斯迪一起在埃及游览,参观古老的人类文明遗迹。在爬完金字塔回来之后,帕特森开始感到腹部疼痛,且无法进食。斯特拉斯迪推断他可能是得了胰腺炎,并将他送到了开罗的医院,三天后,又将他转送到德国法兰克福的一家医院。
对这个装着心脏起搏器且有糖尿病的老人来说,在沙漠中得了胰腺炎,的确是一件糟糕的事情。更糟糕的是,医生很快发现,躲在帕特森内脏中,使他受到感染的细菌,并不是什么容易被收拾的家伙,而是鲍曼不动杆菌。
这是个臭名昭著的超级细菌。
这种细菌被人类发现也有些年头了。起初,它的脾气还算温和,算不上非常致病,医生将它划拉到不会造成明显临床困难的那一类当中。但在最近的 15 到 20 年中,情况渐渐发生了变化。原本好脾气的鲍曼不动杆菌,开始给医生造成困扰——它发展出了针对多种抗生素的耐药性。
“是人们对抗生素的滥用,最终促成了这一变化。”帕特森的主治大夫、加州大学圣地亚哥医学院传染病科主任罗伯特·斯考利,在公开谈论帕特森的病情时说。
1928 年,青霉素被发现,抗生素开始成为抗细菌的主流。
作为医生的武器,抗生素与细菌缠斗了半个多世纪。1990 年左右,具备抗生素耐药性的细菌出现得越来越多。
几乎不怕任何现有抗生素的超级细菌,让医生束手无策。目前世界上有六大超级细菌,它们的名称首字母缩写是“ESKAPE”,而让帕特森感染的鲍曼不动杆菌,是中间的那个“A”。
帕特森被送回加州大学圣地亚哥分校时,已经神志不清了,他体内的不动杆菌,对他身体能够承受的所有抗生素,都已产生了耐药性。细菌渗入在他的血液中,使他产生幻觉,出现脓毒性休克的症状。
斯特拉斯迪开始听到同事讨论她的丈夫会不会死的问题。她坐在病床边上,握着丈夫的手,看着他越来越虚弱。“没有什么能杀死这些虫子,但是你想让我去寻求一些替代疗法吗?”她问昏迷中的帕特森。
就在这时,加州大学旧金山分校的一位同事提到,她的一位朋友接受过噬菌体治疗。斯特拉斯迪记得自己在多伦多大学读本科的时候,曾经学过噬菌体。听到同事的建议,她脑中浮现出了一个惊叹:“哇!”她立刻给罗伯特·斯考利医生写了一封电子邮件:“你觉得噬菌体疗法怎么样?”
“这是个有趣且引人入胜的想法。”斯考利医生回答。
他们开始联络马里兰海军医学实验室与德克萨斯农工大学的相关研究者,以获得针对鲍曼不动杆菌的噬菌体。
美国食品药品监督管理局也批准了这次具有实验性质的治疗方案。在此之前,这两所机构的噬菌体实验最多只在动物模型上使用过,从来没有用于临床。
“我们没有这样做过,但我们认为是时候了。”德克萨斯农工大学的研究者回应斯特拉斯迪。
这个治疗方案几乎是“超现实”的,斯特拉斯迪甚至为此做了个噩梦。在梦里,她端着一个有裂缝的破便盆,四处寻找合适的噬菌体。那个破便盆似乎是丈夫在埃及时用过的,污水从缝隙里都渗了出去,这让她急得醒了过来,想着“我可怎么用这破盆找到噬菌体呢”,随后她才反应过来这只是个噩梦。
对她来说,丈夫的病或许更像个噩梦。2016 年 3 月,当德克萨斯农工大学与马里兰海军医学实验室的噬菌体制剂陆续送来,注射到帕特森的患处和血液中时。这个现实中的噩梦终于也能“醒来”了。
绝大部分噬菌体病毒所携带的基因,都“不知道究竟是干嘛的”,既不能确定是有益的,也无法确认是有害的。
关于帕特森被噬菌体疗法挽救了生命的故事,迅速获得媒体关注,点爆了社交平台。不过,在中国科学院武汉病毒研究所的相关研究者看来,这件事儿“合情合理”。
“中国在上个世纪 50 年代,就有用噬菌体治愈超级细菌感染者的例子。”据危宏平介绍,1958 年,我国的第一位细菌学博士余教授,曾经用能够捕食绿脓杆菌的噬菌体,成功治愈了一位被钢水烫伤后,因铜绿而感染的工人。
当时,绿脓杆菌感染引发了败血症,在使用新研制的多粘菌素抗生素后,患者体内的绿脓杆菌对多粘菌素产生了耐药性。在使用绿脓杆菌噬菌体后,患者的腿避免了被截肢。这个案例甚至被拍成了电影《春满人间》。
在如今的中科院武汉病毒研究所的实验室里,绿脓杆菌和其他细菌一样,正静静躺在培养皿里。
这是一个透明的圆形盒子,大概有成年人的巴掌大小。盒子底部细菌覆盖的区域,是一层半透明的黄色。危宏平拿起这只盒子,给中国青年报·中青在线记者指着看上面几块形状不规则的斑迹。那就是被噬菌体“吃”过的部分。
根据形态结构,噬菌体可以分为 13 个科,其中最常见的,是长尾噬菌体科、肌尾噬菌体科和短尾噬菌体科。大部分的噬菌体都包含在这 3 个科的 15 个属中。“典型的噬菌体,通常有一个 20 面体的头部,一个中空的针状结构及外鞘组成的尾部,以及尾丝和尾针组成的基部。”诊断微生物学学科组副研究员杨航介绍。
噬菌体英文名称的词缀,来源于希腊语的“吃”。而它“吃掉”细菌的过程,则像是一场入侵战争。
这些肉眼不可见的小病毒,会先把自己锚定在宿主细菌的表面,用尾部的酶,将细菌细胞壁的肽聚糖水解,钻出一个小孔,随后将藏在自个儿头部的基因组,注入细菌细胞内,把蛋白质外壳留在外面。经过一轮的复制、装配和裂解之后,噬菌体在细菌细胞内部释放出子代噬菌体,最终将细菌细胞消耗殆尽,自内而外地“吞吃”掉了。
整个“吞吃”周期,通常可以在 20 到 40 分钟内完成,远远快于细菌的繁殖速度。一个感染周期之内,噬菌体能够释放几百个子代,子代又接着感染周围的正常细菌。只需要重复 4 次,一个噬菌体就能让几十亿个细菌感染死亡。
“问题在于,噬菌体是活的,是生物。”杨航对中国青年报·中青在线记者说。尽管普遍认为,噬菌体是安全的,大自然中、人们的日常生活中,也到处都可以接触到噬菌体。但若是想将这些病毒药用,那就是另一个概念了。
“当噬菌体在你的体内捕食细菌时,它们也会在你的身体里穿来穿去,有可能和你进行基因交换。”杨航说。
基因交换是所有病毒都具备的能力,让研究者感到束手束脚的是,绝大部分噬菌体病毒所携带的基因,都“不知道究竟是干吗的”,既不能确定是有益的,也无法确认是有害的。
在下定决心对帕特森使用噬菌体疗法之前,妻子斯特拉斯迪也不得不面临这个未知的风险。
理论上,噬菌体也可以协助传播超级细菌携带的毒素基因和耐药性基因,这会让那些对抗生素产生耐药性的细菌更多。
“因此,研究人员需要在噬菌体被治疗前,对这些基因进行鉴定和筛选。”斯特拉斯迪建议,如果需要的话,可以使用基因编辑工具来分割这些基因。
她和治疗团队所担心的另一个风险,是在治疗过程中,被噬菌体抛弃蛋白质外壳,可能会产生引起脓毒性休克的木糖醇。
幸好,在对帕特森进行治疗时,这种情况并没有发生。
或许噬菌体自己也没想到,最终将它拉出冷宫的,居然是被它当作食物的超级细菌。
在危宏平看来,基因技术的进步,或许也是噬菌体的研究可以重新进入研究者视线的原因之一。
噬菌体的发现,比抗生素早了十几年。1915 年,弗德里克·特沃特在培养葡萄球菌时,发现有一些小病毒正在“吃”他的实验品。此后,许多研究者陆陆续续在噬菌体、支原体、螺旋体、放线菌及蓝细菌中,发现了这种以细菌为食的病毒的身影。
法国微生物学家费利克斯·德赫雷尔是第一个使用噬菌体疗法的学者。当时在巴黎,一场由志贺式菌引发的痢疾疫情肆虐。德赫雷尔作出一个大胆的推断,认为幸存者的粪便中,应该有能够攻击志贺式菌的噬菌体。他成功分离了所需要的噬菌体,接受治疗的孩子们也活了下来。
然而,由于受时代和技术的限制,当时的研究者们没能弄明白噬菌体究竟是什么。德赫雷尔认为它是一种天然的免疫因子,而有的学者则认为,噬菌体只是一种类似细菌分泌物的物质。直到后来基因学逐渐发展起来,研究者们才认识到,噬菌体其实是一种具有遗传性的物质实体。
“当时的研究者没有发现,噬菌体是个很挑食的生物,一种噬菌体几乎只吃一种细菌。这就造成当时的噬菌体疗法,表面看起来有时候见效,有时候又没用。”危宏平说。疗效的不稳定和抗生素的出现,使得噬菌体被西方研究者打入了冷宫,一冷就是 40 多年。
或许噬菌体自己也没想到,最终将它拉出冷宫的,居然是被它当作食物的超级细菌。
由危宏平牵头的学科组,是在 2010 年开始进行噬菌体的立项研究的。目前,诊断微生物学学科组进行的研究,有针对引发湿疹的葡萄球菌的,有应用在农业中,针对常见腐败细菌的。研究生正在培育的一种噬菌体,可以预防和延缓土豆发软发霉的过程。
2006 年,美国批准了多种噬菌体作为食品添加剂使用。噬菌体被用在食品表面,抑制诸如李斯特菌等细菌的繁殖。
“在国外还有用噬菌体调节肠道菌群的研究,有可能用来减肥。”据危宏平介绍,理论上,只需用噬菌体把胖子的肠道菌群调节成瘦子的菌群比例,胖子就可以自然而然地瘦下来。
帕特森的“金字塔感染事件”,让包括危宏平、杨航在内的国内研究者“备受鼓舞”,觉得看到了噬菌体疗法被世界更多国家准入的希望,目前全世界只有在格鲁吉亚噬菌体疗法是合法的。
“是时候考虑制定噬菌体准入法则了,只有在规范的监管框架下,才能促进噬菌体疗法的实施。”杨航说,“也许需要承担一定的风险,但哪有完全没有风险的尝试?由于国内外药物监管体系的缺陷,没有适合于噬菌体审批体系的条款,这就意味着噬菌体将不可能以‘药物’的名义入市。”
帕特森清醒过来之后,了解到自己是被噬菌体治好的,而且给自己使用的这种噬菌体,是从污水中提取分离出来的。
“把净化过的污水泵入你的身体,并让它治愈你的感觉如何?”斯蒂芬妮·斯特拉斯迪开玩笑地问他。
帕特森觉得有点怪,但很高兴自己还活着。“它可能意味着,数百万人在未来有了被治愈的希望。我认为这是医学的未来。”他说。
帕特森出院回到家,一度暂时使用着轮椅,但身体状况在逐渐好转。人们和他谈论他的经历,有一个瞬间,他突然觉得“像是有人在电击我的大脑”,一连串浑浑噩噩阶段的记忆被重新唤醒。
在发现特朗普是总统候选人的那一刻,他还以为自己再次产生了幻觉。

